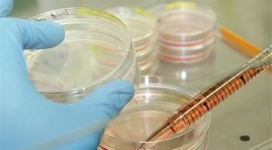
First Successful Human–Pig Hybrid Created in the Lab: A Form of ‘Playing God’?

27 girls and 1 counselor missing after flash flood hits Texas Christian Camp
A sudden flash flood swept through a Christian summer camp in Texas early Friday morning, leaving 27 girls and one adult counselor initially unaccounted for, with 12 still missing as of Sunday.
‘Duck Dynasty’ Star Phil Robertson dies at 79
Phil Robertson, the patriarch of the family featured in the hit reality television show Duck Dynasty, died on May 25, 2025, at his home in West Monroe, Louisiana. He was 79.
Is euthanasia an act of medical complicity? Column by Myung-Jin Lee, "A doctor is a healer, not a killer"
A growing debate surrounding physician-assisted suicide (PAS) has raised fundamental ethical questions about the role of doctors in society. Should medical professionals, whose primary duty is to heal and preserve life, be permitted to assist in ending it? While some argue for the right to die with dignity, others warn of the dangerous implications of normalizing euthanasia. The essence of medical ethics is at stake, and the global medical community continues to grapple with this contentious iss
Plan your New Year goal of balancing body and soul with a Christian health trainer!
As the New Year begins, if your resolution is solely focused on living a healthy spiritual life, consider adding another priority: physical health.
-

Man Was Dead for 90 Minutes, Comes Back to Life and Shocks Doctor
A 32-year-old man named T.J. Scanlon from Maryland fell down from 20-foot staircase last March and clinically died for about 90 minutes before coming back to life and shocking his doctor, Dr. H Neal Reynolds.
-
2017 Mount Everest Death Toll: 10 And Counting
For whom the bell tolls, how many people have failed to make it back alive from Mt. Everest in 2017?
-
Irregular Heartbeats? Chocolate Might Be Able To Help
Chocolate is definitely one of the favorite snacks worldwide that everyone loves, but it seems that the latest study points to it being useful in reducing the risk of an irregular heartbeat.
-
Cancer Prevention: Doctors Find These Simple Steps Helpful for Cancer Survivors to Live Longer
People diagnosed with advanced cancer can follow a way that can help them live longer, and it does not call for traditional methods such as surgery or chemotherapy. It can simply be done by eating right and increasing your time for exercise, doctors noted on Wednesday.
-
Michael Bublé's Wife Says Son Noah's Miraculous Cancer Recovery Strengthened Her Faith in God
Michael Bublé's wife, Luisana Lopilato, has said their son, Noah, is doing well after being diagnosed with liver cancer - and that her son's miraculous recovery strengthened her faith in God.
-
4 Y/O Boy Miraculously Recovers After Drowning: 'I Had Faith God was Going to Heal Him'
In what doctors can only describe as a "miracle", a 4-year-old boy who fell into a swimming pool and was underwater for nine minutes has made a full recovery after his mother tirelessly prayed for his healing.
-

Why Does God Allow Pain and Suffering?
It has been described as a searing of the soul, a rending of the heart. C. S. Lewis aptly called it a "problem." And yet the Bible says that there is no such thing as a Christian without it: Pain. Perhaps the most difficult pain, Lewis addresses moreover, is the matter of emotional, or mental, pain.
-

3 Ways to Overcome Stress and Become Heaven-Minded
The concerns of this life can be overwhelming at times, and if we are not careful to guard ourselves, stress can hit us pretty badly. However, as believers, we have been given the fulfillment of all of God’s promises in Christ and we do not have to live from day to day being consumed by the issues of life.
-

Gay Lifestyle Drug Gets Approved in Scotland
The Scottish Medicine Consortium gave its approval for the use of the controversial gay lifestye drug, making Scotland the first in the U.K. to legally allow its use.
-

Porn Has Been Declared a Public Health Crisis, Here's Why...
Two state governments in America have now declared pornography a public health crisis, with two more on the way, while the church is lagging behind with only 7% of pastors say that they have a program for those struggling with porn.
-

Christian Husband Asks for Prayers for Wife Who is Allergic to Him, Fainted in New Home He Built for Her
A Minnesota man whose wife is allergic to everything - including her spouse - has asked for prayers for healing after she collapsed in the home he spent a year renovating for her.
-

Nanny Donates Part of Her Liver to Sick Baby, Becomes Answer to Family’s Prayer
A 22-year-old babysitter became the answer to a family’s prayer when she decided to donate part of her liver to the baby she was taking care of.
-

How Detention and Deportation Inflict Psychological Trauma on Latino Citizen Children: Study
Immigration is a contentious political debate, but what are the psychological effects on families when deportations occur? U.S. citizen children of immigrants, a large segment of the U.S. child population, have diverse mental health needs. How these needs are met - or ignored - by current public policies and practices can have long-term consequences for the development and well-being of this vulnerable population.
-
First Successful Human–Pig Hybrid Created in the Lab: A Form of ‘Playing God’?
For the first time in history, scientists were able to successfully create a hybrid of a human and an animal.


